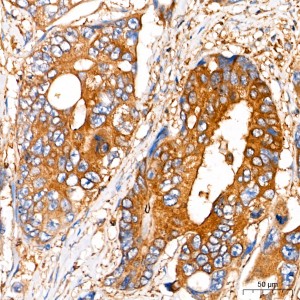
KO-Validated Insulin-degrading enzyme (IDE) Rabbit pAb (20 μl)

KO-Validated Insulin-degrading enzyme (IDE) Rabbit pAb (20 μl)
| Reactivity: | Human, Mouse |
| Applications: | WB, IHC, IF/IC, ELISA |
| Host Species: | Rabbit |
| Isotype: | IgG |
| Clonality: | Polyclonal antibody |
| Gene Name: | insulin degrading enzyme |
| Gene Symbol: | IDE |
| Synonyms: | INSULYSIN; E) |
| Gene ID: | 3416 |
| UniProt ID: | P14735 |
| Immunogen: | Recombinant fusion protein containing a sequence corresponding to amino acids 1-250 of human Insulin-degrading enzyme (Insulin-degrading enzyme (IDE)) (NP_004960.2). |
| Dilution: | WB 1:500-1:2000; IHC 1:50-1:200; IF/IC 1:10-1:100 |
| Purification Method: | Affinity purification |
| Concentration: | 1.29 mg/ml |
| Buffer: | PBS with 0.09% Sodium azide, 50% glycerol, pH7.3. |
| Storage: | Store at -20°C. Avoid freeze / thaw cycles. |
| Documents: | Manual-IDE polyclonal antibody |
Background
This gene encodes a zinc metallopeptidase that degrades intracellular insulin, and thereby terminates insulins activity, as well as participating in intercellular peptide signalling by degrading diverse peptides such as glucagon, amylin, bradykinin, and kallidin. The preferential affinity of this enzyme for insulin results in insulin-mediated inhibition of the degradation of other peptides such as beta-amyloid. Deficiencies in this protein's function are associated with Alzheimer's disease and type 2 diabetes mellitus but mutations in this gene have not been shown to be causitive for these diseases. This protein localizes primarily to the cytoplasm but in some cell types localizes to the extracellular space, cell membrane, peroxisome, and mitochondrion. Alternative splicing results in multiple transcript variants encoding distinct isoforms. Additional transcript variants have been described but have not been experimentally verified.
Images
 | Western blot analysis of various lysates using [KO Validated] Insulin-degrading enzyme (IDE) Rabbit pAb (A1630) at 1:1000 dilution. Secondary antibody: HRP-conjugated Goat anti-Rabbit IgG (H+L) (AS014) at 1:10000 dilution. Lysates/proteins: 25μg per lane. Blocking buffer: 3% nonfat dry milk in TBST. Detection: ECL Basic Kit (RM00020). |
 | Western blot analysis of lysates from wild type (WT) and Insulin-degrading enzyme (Insulin-degrading enzyme (IDE)) knockout (KO) HeLa cells, using [KO Validated] Insulin-degrading enzyme (IDE) Rabbit pAb (A1630) at 1:1000 dilution. Secondary antibody: HRP-conjugated Goat anti-Rabbit IgG (H+L) (AS014) at 1:10000 dilution. Lysates/proteins: 25μg per lane. Blocking buffer: 3% nonfat dry milk in TBST. Detection: ECL Basic Kit (RM00020). Exposure time: 10s. |
 | Immunohistochemistry analysis of paraffin-embedded Human colon carcinoma tissue using [KO Validated] Insulin-degrading enzyme (IDE) Rabbit pAb (A1630) at a dilution of 1:200 (40x lens). High pressure antigen retrieval performed with 0.01M Citrate Buffer(pH 6.0) prior to IHC staining. |
 | Immunofluorescence analysis of A549 cells using [KO Validated] Insulin-degrading enzyme (IDE) Rabbit pAb (A1630). Secondary antibody: Cy3-conjugated Goat anti-Rabbit IgG (H+L) (AS007) at 1:500 dilution. Blue: DAPI for nuclear staining. |
You may also be interested in: